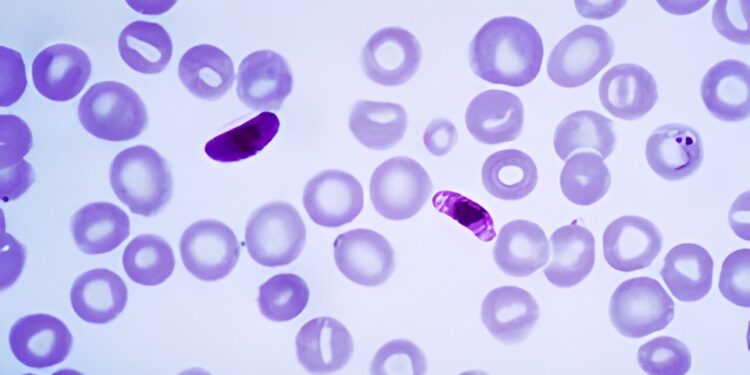
Synthetic compound shows promise against susceptible and drug-resistant strains of human malaria parasites

This photomicrograph of a blood smear contains a macro and microgametocyte of the parasite Plasmodium falciparum. Credit: Wikipedia.
In 2022, nearly 619,000 deaths worldwide from malaria were caused by Plasmodium falciparum, the most virulent, widespread and deadly human malaria parasite. For decades, the parasite’s resistance to all antimalarial drugs has posed a significant challenge to researchers trying to stop the spread of the disease.
A team led by scientists from UC Riverside, UC Irvine and the Yale School of Medicine has now designed a new malaria drug and identified its mechanism of action. Researchers found that the drug, called MED6-189, is effective against drug-susceptible and drug-resistant strains of P. falciparum in vitro as well as in a humanized mouse model (the mice were engineered to have human blood).
The researchers report in the journal Science that MED6-189 acts by targeting and disrupting not only the apicoplast, an organelle present in P. falciparum cells, but also vesicular trafficking pathways. They discovered that this dual mode of action prevents the pathogen from developing resistance, making this drug a very effective antimalarial compound and a promising new avenue in the fight against malaria.
“Disruption of apicoplast and vesicular trafficking blocks parasite development and thus eliminates infection of red blood cells and our humanized mouse model of P. falciparum malaria,” said Karine Le Roch, professor of molecular, cellular and systems biology. at UCR and the lead author of the paper.
“We found that MED6-189 was also potent against other zoonotic Plasmodium parasites, such as P. knowlesi and P. cynomolgi.”
MED6-189 is a synthetic compound inspired by a compound extracted from marine sponges. The lab of Christopher Vanderwal, professor of chemistry and pharmaceutical sciences at UC Irvine, synthesized the compound.
The photo shows four co-authors of the research paper. From left to right: Zeinab Chahine (first author of the research document), Karine Le Roch, Thomas Hollin and Jacques Prudhomme. Credit: Stan Lim, UC Riverside.
“Most of the best antimalarial agents are or are derived from natural products,” he said.
“For example, artemisinin, originally isolated from sweet wormwood, and its analogues, are of crucial importance for the treatment of malaria. MED6-189 is a close relative of a different class of natural products, called isocyanoterpenes , which appear to target multiple pathways in P. falciparum, this is beneficial because if only one pathway had been targeted, the parasite could develop resistance to the compound more quickly.
When researchers at GSK, a Spanish pharmaceutical company, gave MED6-189 to mice infected with P. falciparum, they found that it rid them of the parasite.
Working with Choukri Ben Mamoun, professor of medicine and microbial pathogenesis at the Yale School of Medicine, the team also tested the compound against P. knowlesi, a parasite that infects monkeys, and found that it worked as expected , eliminating the monkey parasite. infected red blood cells.
Next, the team plans to continue optimizing MED6-189 and further confirm the mechanisms of action of the engineered compound using a systems biology approach. Systems biology is a biomedical research approach aimed at understanding the broader picture of a biological system. It offers researchers a way to examine how different living organisms and cells interact on a larger scale.
Le Roch, Vanderwal and Ben Mamoun were joined in the research by fellow scientists from the Stowers Institute for Medical Research in Kansas City, Missouri; GSK; and the University of Georgia.
More information:
Z. Chahine et al, A kalihinol analogue disrupts apicoplast function and vesicular trafficking in P. falciparum malaria, Science (2024). DOI: 10.1126/science.adm7966. www.science.org/doi/10.1126/science.adm7966
Provided by University of California – Riverside
Quote: Synthetic compound shows promise against drug-susceptible and drug-resistant strains of human malaria parasites (September 26, 2024) retrieved September 26, 2024 from
This document is subject to copyright. Except for fair use for private study or research purposes, no part may be reproduced without written permission. The content is provided for informational purposes only.